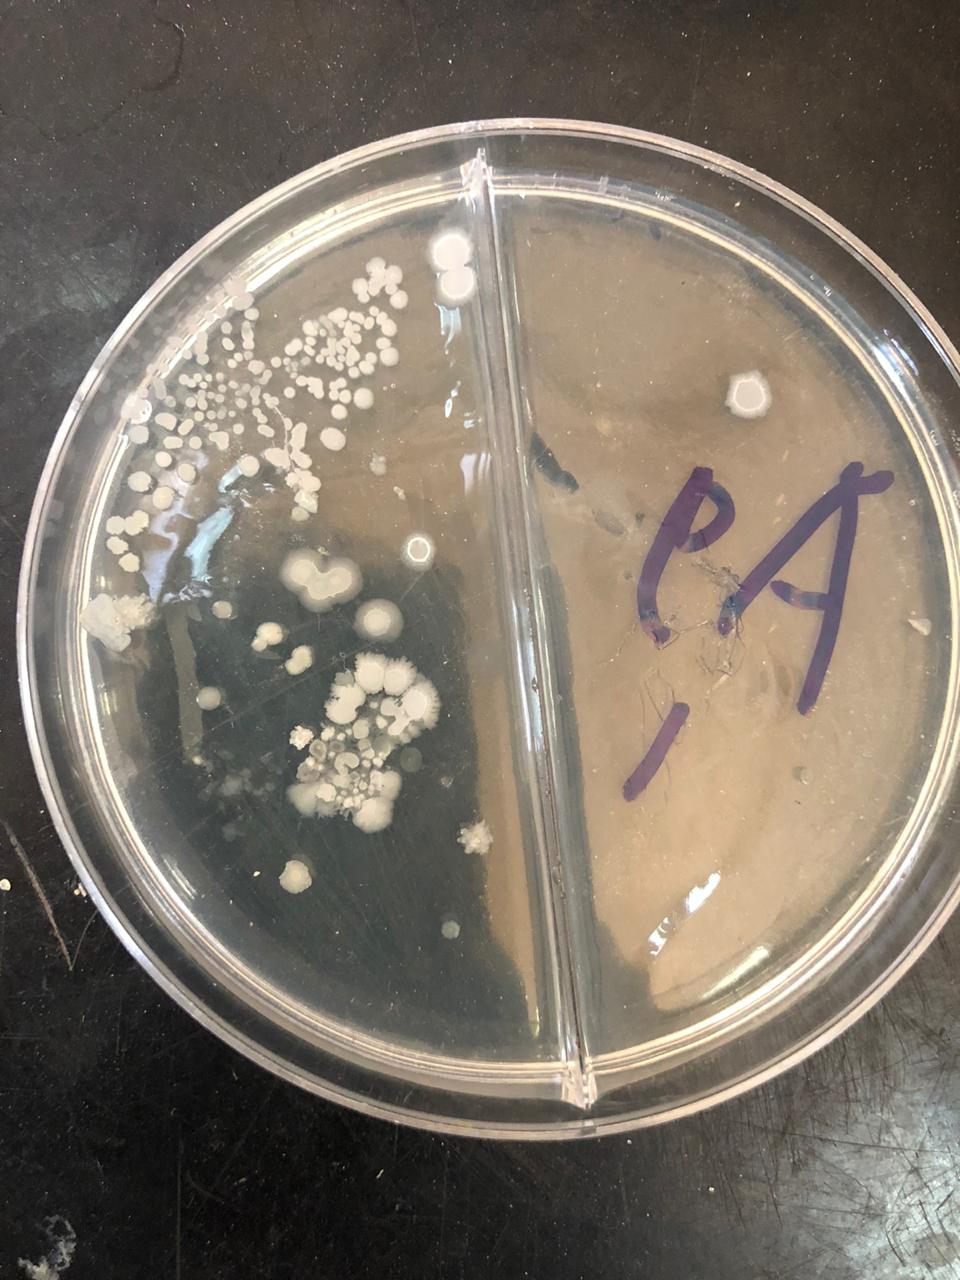
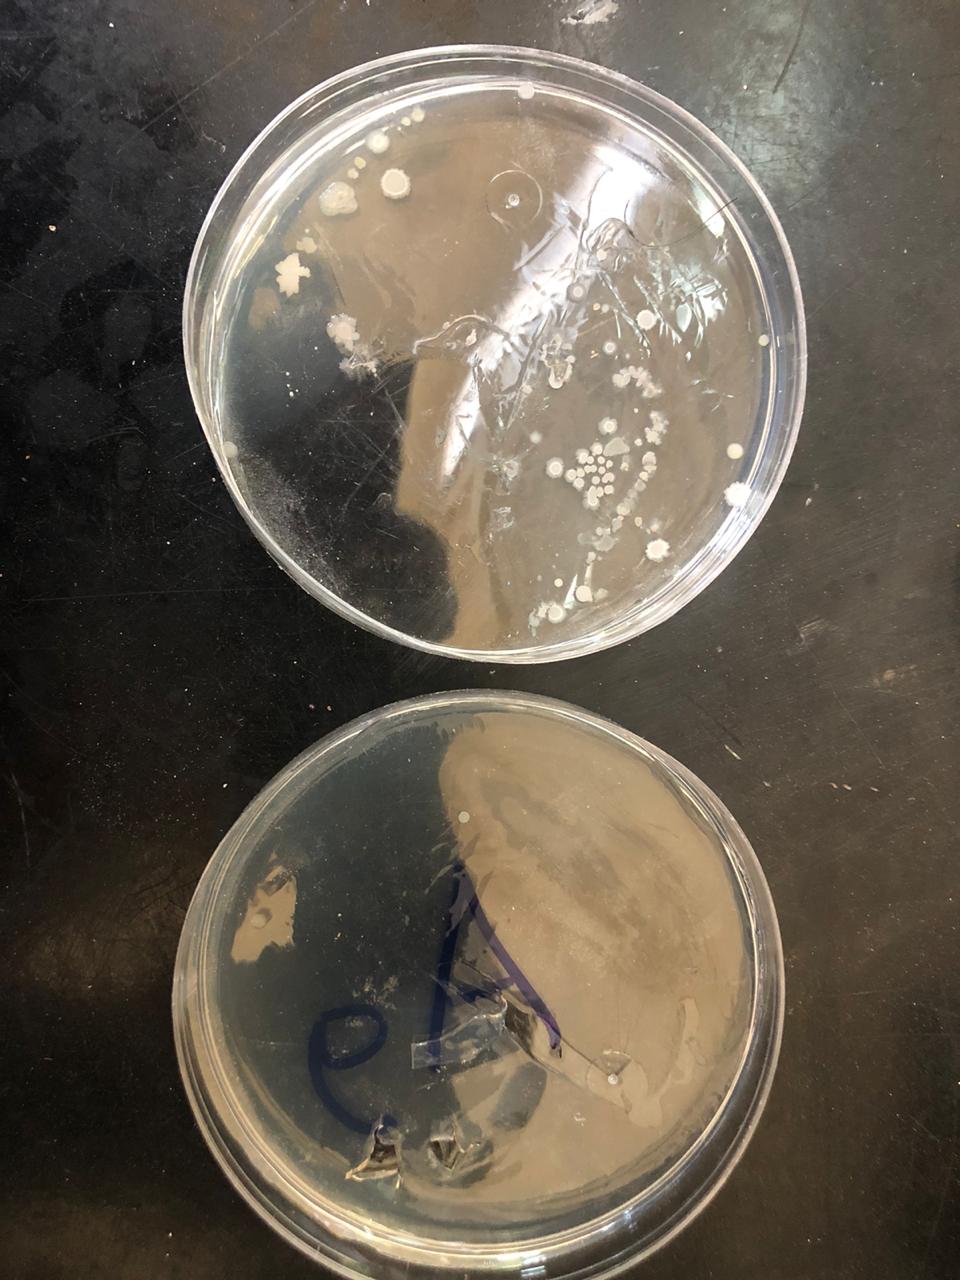

- محطات و معلومات فى حياة الموسيقار بليغ حمدى ملك الموسيقى
- بليغ حمدى أدخل أساليب جديدة فى الألحان وغير شكل الاغنية المصرية
- "اعمل الخير وارميه البحر"..قول مرفوض والعمل الصالح يُقبل بشرط
- بين الخلافات والنجاحات..قصة الموسيقار بليغ حمدى و عبد الحليم حافظ
- قصص 7 حكايات فى حياة الموسيقار بليغ حمدى من جميلات الوسط الفنى
أبحاث قابلة للتطبيق لمواجهة الفيروس
رئيس مركز بحوث الفلزات: نقدم معقمات بديلة للكلور والكحول.. صديقة للجهاز التنفسي

ويقدم المركز نتائج ناجحة لمعمل معالجة وحماية السطوح »شعبة تكنولوجيا الفلزات« لدمج جسيمات الفضة النانوية فى مجموعة واسعة من المنتجات ومنها مطهر ومعقم بديلا عن الكحول والكلور، مطهر ومعقم للاستخدامات الشخصية »سائل وجل«، تصميم وتنفيذ منتج كمامة.
ومن جانبه، أوضح الدكتور مأمون عبد الحميد الباحث بمعمل معالجة وحماية السطوح بشعبة تكنولوجيا الفلزات، ان أول منتج »مطهر بديل للكحول« يستخدم في عمليات الرش على مجموعة متنوعة من الأسطح، بما في ذلك الجدران، والأرضيات، والأحواض، ومقابض الأبواب، وأغطية مفاتيح الكهرباء، والهواتف والأجهزة، والطاولات والكراسي، وأسطح المطابخ، ويمكن استخدامها في كل من الأماكن السكنية والمؤسسية مثل المستشفيات، والمطاعم، والمدارس، والأسواق، والمصانع، والورش، ودور العبادة، والمكاتب والشركات، وجميع الأسطح التي يتم تلامسها أو التعامل معها مثل الملابس وأيضا صناديق القمامة، والأثاث الداخلي والخارجي، وألعاب الأطفال، وغيرها من معدات وأماكن الترفيه، ومن مميزات هذا المطهر استمرار فعاليته في تطهير الأسطح على الرغم من شطفها بالماء،كما أنه يختلف عن محاليل الكلور شديدة التأثير السلبي للأسطح، وذات رائحة مهيجة للجهاز التنفسي.

وأضاف د. مأمون ان المطهرات الشخصية تستخدم فى تعقيم الأيدي والأسطح المكشوفة من جلد الأنسان، وأيضا الحيوانات، ويختلف هذا المنتج عن المنتجات التى تعتمد على الكحول في التطهير، حيث أن زيادة التعقيم بالكحول تجعل الجلد جافا ويبدأ في التشقق، وهذه الشقوق تعطي الجراثيم مكانًا للاختباء وسهولة الإصابة بالميكروبات، وأيضا خطورة الكحول فى سهولة الاشتعال وحدوث حروق للجلد.
وأشار الباحث الى الكمامة الشخصية حيث انها تتميز بجودتها، ولا يتم التخلص منها، ويتم فقط تغيير فلتر معالج بالفضة النانونية، وذلك للحد من العدوى البكتيرية والفيروسية الناتجة عن التخلص الغير آمن للكمامات المستخدمة حاليا، والتى يتم تصنيفها ضمن النفايات الطبية الخطرة.
كما تستخدم أكثر من مرة، وتناسب جميع الأعمار ولجميع الأماكن العامة والخاصة، ولجميع الوظائف المهنية وأيضا داخل الأماكن عالية الكثافة ومنها معسكرات التدريب والتأهيل.
وأكد رئيس المركز ان جميع المنتجات تتميز باحتوائها على جزيئات الفضة النانوية ومركبات أخرى لها خواص التطهير والتعقيم، حيث يتم ثبات جسيمات الفضة النانوية على الأسطح بعد الانتهاء من عمليات التطهير، وذلك من خلال تكون طبقة رقيقة تحتوي على جسيمات الفضة النانوية »فيلم حيوي« على الأسطح، والذى يعمل على استمرارية تطهيرها بدرجة مناسبة حتي إعادة عملية التطهير مرة أخرى.
والتركيبات المقدمة من مركز بحوث وتطوير الفلزات، تتميز بأنها أمنة بيئيا ومحضرة بطرق صديقة للبيئة ويغلب عليها صفة المركبات الطبيعية والآمنة صحيا، وقد تم تجربة المخرجات السابقة على وقف نمو وقتل الأنواع المختلفة من البكتيريا، عن طريق استخدام المزارع البكتيرية على أوساط مختلفة.








اترك تعليق